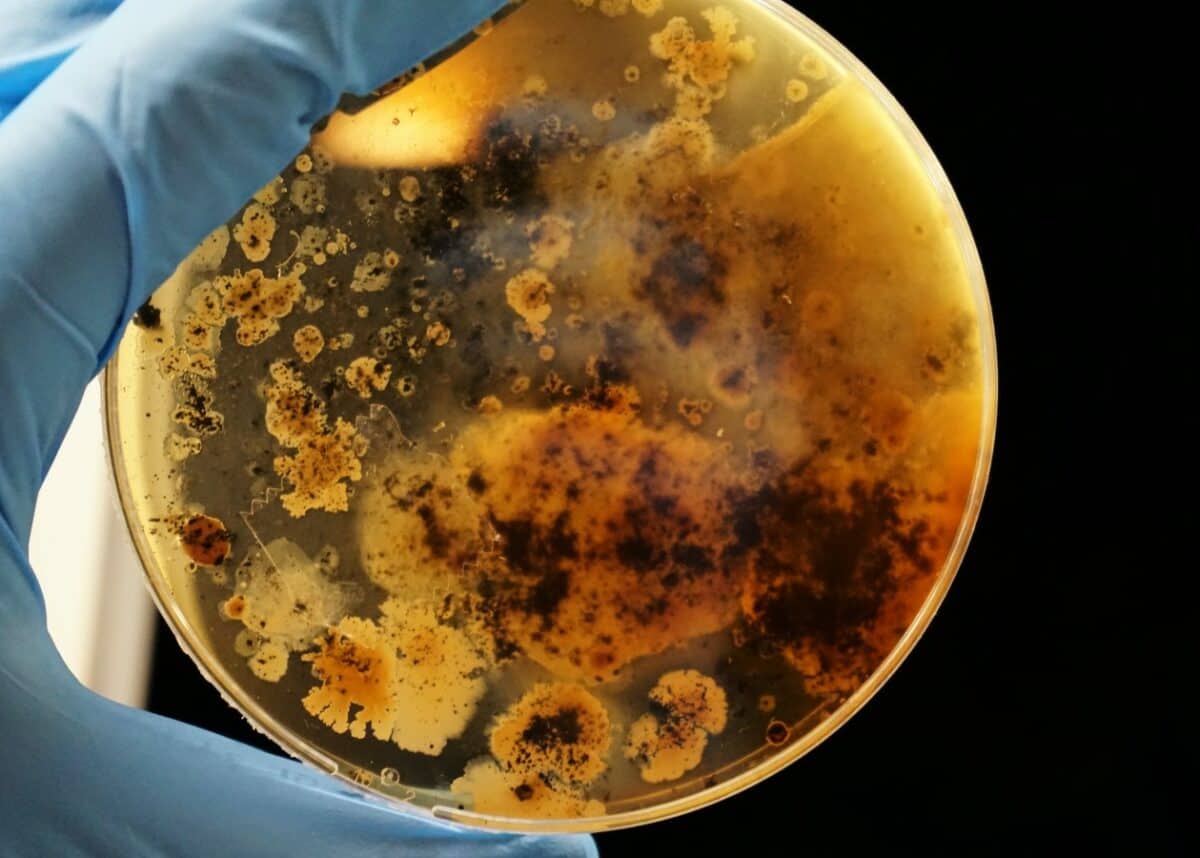
Photo by Adrian Lange on Unsplash

Nial Wheate, University of Sydney
The world is now 18 months into the COVID-19 pandemic and we’ve yet to find a single drug that can stop the virus. At best, we can treat the effects of the virus through oxygen therapy for those who can’t breathe, and with drugs that reduce the inflammation associated with the infection.
But an Australian-United States research team, led by Griffith University’s Menzies Health Institute, have shown promising results in their mouse trials of a new treatment for COVID-19.
The technology is based on “short interfering RNA”, which prevents the virus from replicating inside human cells. They found a 99.9% drop in the number of virus particles in the mice they studied.
The researchers hypothesise the drug could be injected into patients daily for up to five days, for example for sick patients in hospital, or as a once-off if someone has just been exposed to the coronavirus; however, there’s no data on this specifically, so it’s speculative for now.
While the results are very promising, the technology has only been tested in mice. Human clinical trials will take some time to complete before we know whether a drug will be approved by the government.
How viruses work
Viruses are tricky to treat because they are biological molecules made of the same types of materials as the human body. Virus particles are just packets of information on how to make more virus, encoded in a molecule called “ribonucleic acid” or RNA (although some contain DNA instead) within a protein coating.
Once a virus particle penetrates into a cell, it either hijacks the machinery of the cell to make copies of itself, or in some cases, has its RNA copied into the host cell’s DNA. Either way, the cell becomes a manufacturing facility making hundreds and thousands of copies of the virus.
So the best way to stop a virus is to stop its RNA information being copied and transcribed by the cell.
We already have drugs capable of doing this for specific viruses. A drug called PrEP (pre-exposure prophylaxis) is available as a prophylactic against infection with HIV and the development of AIDS. A prophylactic can prevent a disease before it takes hold in the body.
The PrEP medicine works because the two active ingredients it contains, tenofovir and emtricitabine, block a molecule called reverse transcriptase which the virus needs to be replicated. Unfortunately, neither drug works to block COVID-19.
Short interfering RNA
Unlike PrEP, the new technology is particularly clever because it uses a molecule called short/small interfering RNA or “siRNA” to prevent the reading and copying of the virus information. This siRNA was specifically designed to recognise a sequence of the coronavirus’ own RNA that is common across COVID-variants.
This means the siRNA can seek out and lock onto the viral RNA because it perfectly complements it, regardless of the COVID-19 strain. When it locks with the virus RNA, the viral information becomes trapped and can’t be copied, or it causes the RNA to be cut and degraded.
At this point there is no virus production, and our immune system can just mop up the small number of virus particles floating around the body.
To prove their technology, the researchers enclosed their siRNA in lipid nanoparticles, which are essentially tiny fat-like particles. Without this protective coating, the siRNA would be destroyed in the blood stream before it could lock onto the virus. Lipid nanoparticles are also used in the formulation of the Pfizer and Moderna COVID-19 vaccines.
With the protective nanoparticle shell, the siRNA could then be delivered via a water-based injection into veins.
When the researchers administered the siRNA to mice that had been infected with COVID-19, they found the mice didn’t lose as much weight when compared with untreated mice. Weight loss was an indicator of how sick the mice were.
The researchers also found a 99.9% drop in the number of virus particles in the mice.
On occasion, when biological molecules are injected into the blood stream, this can trigger a severe allergic reaction called anaphylaxis. Importantly, the researchers found their siRNA didn’t trigger an immune response in the mice, and therefore will be unlikely to cause anaphylaxis.
So as well as being effective, the technology appears to be relatively safe.
Will this drug be available soon?
As promising as the results are, we shouldn’t get our hopes up that a drug will be available any time soon. Data derived from animal tests doesn’t always translate to success in humans. Often, the way an animal’s body processes a drug can be different from the human body, and it ends up being ineffective.
Also, animal tests are just the first step in a long regulatory process to prove a drug works and is safe. Even with accelerated clinical trials and fast-tracked assessment from governments, an approved drug is still a year or more away.
Correction: a previous version of this article stated that HIV needed reverse transcriptase to embed the RNA information into human DNA. We’ve amended it to say HIV needs reverse transcriptase to be replicated.
Nial Wheate, Associate Professor of the Sydney Pharmacy School, University of Sydney
This article is republished from The Conversation under a Creative Commons license. Read the original article.